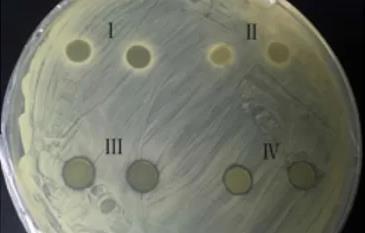
體外抗菌活性測定

注意:因業(yè)務(wù)調(diào)整,暫不接受個人委托測試,望見諒。
北檢院檢測機構(gòu)介紹
體外抗菌活性測定應(yīng)該去哪里?北檢院檢測平臺-[生物醫(yī)藥實驗室]可提供體外抗菌活性測定服務(wù),具有豐富的檢測經(jīng)驗。各個領(lǐng)域設(shè)立專項測定室,能力覆蓋材料、生物、醫(yī)藥研究、醫(yī)療器械、化妝品、組學(xué)測定、消殺產(chǎn)品、土壤檢測、危廢鑒別、儀器測定等。北檢院生物醫(yī)藥實驗室,可根據(jù)體外抗菌活性測定的相關(guān)檢測標(biāo)準(zhǔn),并提供體外抗菌活性測定報告,可在全國范圍內(nèi)使用并被認(rèn)可。
測定周期:7-15個工作日
測定費用:工程師根據(jù)檢測項目進行報價
測定項目
左氧氟沙星體外抗菌活性測定,腸球菌體外抗菌活性測定,中藥材體外抗菌活性測定,頭孢體外抗菌活性測定,奧硝唑體外抗菌活性測定,白芨體外抗菌活性測定,環(huán)丙沙星體外抗菌活性測定,精氨酸體外抗菌活性測定,甲硝唑體外抗菌活性測定,頭霉素類體外抗菌活性測定,喹諾酮類體外抗菌活性測定等。
體外抗菌活性實驗介紹
體外抗菌實驗:體外條件下,測定細(xì)菌/真菌對測試樣品的敏感程度。體外抗菌實驗分為抑菌實驗和殺菌實驗,抑菌實驗可測定僅有抑制細(xì)菌/真菌生長繁殖而無殺滅作用的測試樣品;殺菌實驗可測定不僅抑制而且能殺滅細(xì)菌/真菌的測試樣品。
抑菌實驗方法有OD值法、抑菌圈法、共培養(yǎng)+平板涂布計數(shù)法(一般培養(yǎng)環(huán)境為細(xì)菌/真菌培養(yǎng)基)、MIC。
殺菌實驗方法有共培養(yǎng)+平板涂布計數(shù)法(一般培養(yǎng)環(huán)境為PBS/生理鹽水溶液)、MBC。
測定參考標(biāo)準(zhǔn)
YY/T 0688.1-2008臨床實驗室檢測和體外診斷系統(tǒng) 感染病原體敏感性試驗與抗菌劑敏感性試驗設(shè)備的性能評價
GB/T27623.1-2011 漁用抗菌藥物藥效試驗技術(shù)規(guī)范 第1部分:常量肉湯稀釋法 藥物敏感性試驗
北檢院測定服務(wù)流程是什么?
1、確定需求,與工程師進行溝通,提供方案。
2、接收樣品,多渠道接收樣品(支持郵寄、上門取樣)。
3、測定測定,工程師進行樣品測定。
4、出具報告,根據(jù)樣品測定結(jié)果,提供科學(xué)嚴(yán)謹(jǐn)?shù)膱蟾妗?/p>
5、售后服務(wù),寄送發(fā)票及報告,跟進后續(xù)技術(shù)支持。
以上就是關(guān)于體外抗菌活性測定的相關(guān)內(nèi)容,更多測定需求,你可聯(lián)系我們在線測定室工程師,為您詳細(xì)洽談測定周期及流程問題!
檢測流程
1、收到客戶的檢測需求委托。
2、確立檢測目標(biāo)和檢測需求
3、所在實驗室檢測工程師進行報價。
4、客戶前期寄樣,將樣品寄送到相關(guān)實驗室。
5、工程師對樣品進行樣品初檢、入庫以及編號處理。
6、確認(rèn)檢測需求,簽定保密協(xié)議書,保護客戶隱私。
7、成立對應(yīng)檢測小組,為客戶安排檢測項目及試驗。
8、7-15個工作日完成試驗,具體日期請依據(jù)工程師提供的日期為準(zhǔn)。
9、工程師整理檢測結(jié)果和數(shù)據(jù),出具檢測報告書。
10、將報告以郵遞、傳真、電子郵件等方式送至客戶手中。
檢測實驗室(部分)




檢測優(yōu)勢
1、綜合性檢測技術(shù)研究院等多項榮譽證書。
2、檢測數(shù)據(jù)庫知識儲備大,檢測經(jīng)驗豐富。
3、檢測周期短,檢測費用低。
4、可依據(jù)客戶需求定制試驗計劃。
5、檢測設(shè)備齊全,實驗室體系完整
6、檢測工程師專業(yè)知識過硬,檢測經(jīng)驗豐富。
7、可以運用36種語言編寫MSDS報告服務(wù)。
8、多家實驗室分支,支持上門取樣或寄樣檢測服務(wù)。
結(jié)語
以上是關(guān)于體外抗菌活性測定的檢測服務(wù)介紹,僅展示了部分檢測樣品和檢測項目,如有其它需求或疑問請咨詢在線工程師。







